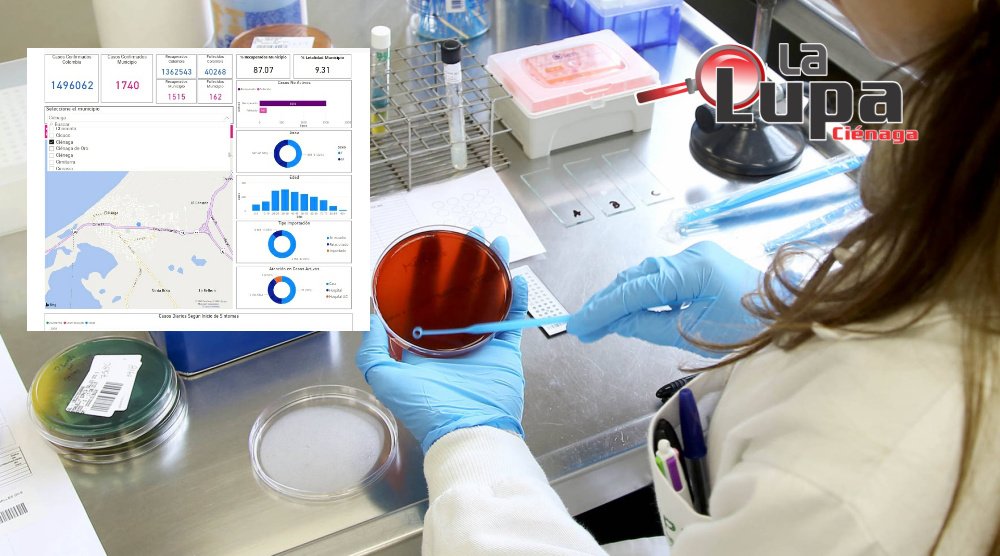

El Instituto Nacional de Salud informó el sábado 19 de diciembre, cinco (5) casos positivos en Ciénaga.
La cifra total de diagnósticos positivos durante la pandemia, pasó de 1.735 a 1.740.
El Instituto Nacional de Salud reporta que no hubo fallecidos en Ciénaga, el sábado 19 de diciembre.
La cifra total de muertes de pacientes con Covid 19, según el INS se mantuvo en 162.
La autoridad sanitaria precisa que hasta la fecha hay 1.515 recuperados (87.07%) y 63 pacientes activos.
El Instituto Nacional de Salud indica que en Ciénaga 847 hombres y 893 mujeres, han dado positivo para Covid 19 durante la pandemia.
Síguenos en la web: www.lalupacienaga.com.co